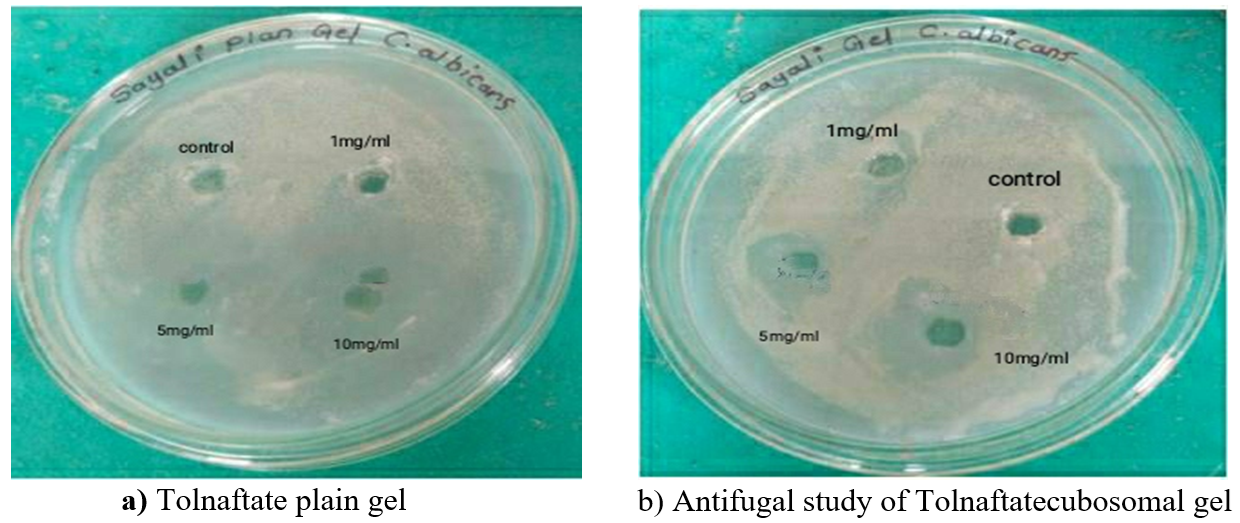

Int J Curr Pharm Res, Vol 17, Issue 1, 33-42Original Article
FORMULATION OF TOLNOFTATE LOADED CUBOSOMES FOR EFFECTIVE TRANSDERMAL DELIVERY: AN IN VITRO AND EX-VIVO STUDY
SAYALI T. PATILa, HARSHADA I. PATILa*, ARCHANA V. VANJARIb, KIRAN A. WADKARc
aDepartment of Pharmaceutics, Dr. Shivajirao Kadam College of Pharmacy, Kasabe Digraj-416305, Sangli, Maharashtra, India. bDepartment of Pharmacology, Dr. Shivajirao Kadam College of Pharmacy, Kasabe Digraj-416305, Sangli, Maharashtra, India. cDepartment of Pharmacognosy, Dr. Shivajirao Kadam College of Pharmacy, Kasabe Digraj-416305, Sangli, Maharashtra, India
*Corresponding author: Harshada I. Patil; *Email: drharshadapatilskcp@gmail.com
Received: 20 Oct 2024, Revised and Accepted: 05 Dec 2024
ABSTRACT
Objective: The novel topical application has several benefits over traditional dosing forms, such as preventing gastrointestinal discomfort, lowering liver drug metabolism, and increasing medication bioavailability. Tolnaftate is used as potential anti-fungal agent various fungal infections.
Methods: The cubosomes were formulated by emulsification technique using probe sonicator. The formulation was optimized using different concentrations of glyceryl monooleate and poloxamer 407.
Results: The formed cubosomes dispersion was subjected to entrapment efficiency, surface morphology, particle size, in vitro release, anti-fungal study and ex-vivo study. The improved formulation was then transformed to a cubosomal hydrogel by the addition of carbopol 934. The average particle size of the optimised cubosomes was 208.0 nm. Zeta potential has been found to be 49.8 mV, with an entrapment efficiency of almost 90.0%. The drug steady-state flux (Jss) values for Tolnaftate Cubosomal formulation, marketed formulation, and plain drug gel were nearly 11.98, 10.23, and 10.06 g/cm2. h. As compared to standard marketed preparation, the cubosome-loaded formulation demonstrated enhanced penetration, extended deposition, and prolonged drug release.
Conclusion: The drug had low solubility and permeability; it was overcome and produced superior outcomes in the form of cubosomes, which considerably increased the drug's solubility and permeability.
Keywords: Cubosomes, Tolnaftate, Topical cubosomal gel, In vitro drug release, Ex vivo skin permeation and skin penetration
© 2025 The Authors. Published by Innovare Academic Sciences Pvt Ltd. This is an open access article under the CC BY license (https://creativecommons.org/licenses/by/4.0/)
DOI: https://dx.doi.org/10.22159/ijcpr.2025v17i1.6016 Journal homepage: https://innovareacademics.in/journals/index.php/ijcpr
INTRODUCTION
A vesicular drug delivery system is a highly ordered assembly of one or more concentric bilayers that is produced when amphiphilic building blocks self-assemble in the presence of water. Because they can concentrate the medication at the site or organ of action by diminishing its concentration at other body locations, they are especially crucial for the targeted delivery of pharmaceuticals [1].
Cubosomes can be considered as a novel lipid-based nanosystem. Recently, cubosomes have been used in oral, ophthalmic, dermatological, and cancer therapies. Cubosomes are attracting particular attention as a novel drug delivery system. Cubosomes are nanoparticles with diameters between 10 and 500 nm. They resemble a square, slightly round spots. Each dot indicates the presence of an aqueous cubic phase-containing pore in the lipid water system [2].
Discrete, sub-micron-sized, nano-structured cubosomes are a type of discontinuous cubic liquid crystalline phase [3]. Such new particles are used to encase poorly water-soluble medicinal compounds. Numerous novel drug delivery methods, like liposomes, cubosomes, and solid lipid nanoparticles, have improved the penetration of anti-fungal medications into the skin, reducing irritation and delivering high local concentration for an extended length of time [2].
Cubosomes are most likely composed of polar and non-polar polymers, lipids, and surfactants, which is why they are referred to as amphiphilic. The amphiphilic molecules are spontaneously identified and accumulate into a nanometer-sized liquid crystal by the hydrophobic action in the polar solvent. Consequently, cubosomes are bicontinuous cubic liquid phases with two unique water zones divided by bilayers controlled by surfactants [3].
Longer-lasting, colloidally and/or thermodynamically stable particle dispersions can be produced when the cubic phase fragments. Cubosomes are essential to the synthesis of nanodrug formulations. Unlike other liquid crystalline systems that transform into micelles at higher dilution levels, cubosomes remain stable almost at any dilution level because of the relative insolubility of the lipid that forms the cubic phase in water [4]. Cubosomes can, therefore, be conveniently added to product compositions. Typically, large energy dispersion of bulk cubic phase results in the production of cubosomes [5, 6].
Cubosomes and nanoparticle delivery systems offer a novel way to reduce side effects while maintaining the effectiveness of anti-fungal medications. Ensure sustained release or increase the skin's ability to absorb drugs [7]. Due to their bilayers composition and structure, the benefits of novel topical administration include increased effectiveness and assured localization or skin penetration of the medicine. When cubosomal medications are administered in semisolid dose forms (gel or cream), high patient compliance can be attained.
The prime objective of cubosomes is to avoid undesirable side effects, increase medicine availability at the location of the disease, and manage drug degradation and loss [8]. Developing vesicular methods for prolonged topical administration is a novel trend. Because of their higher viscosity, the lipid components of these vesicles enhance skin penetration and skin residence time. Recently, there has been an increasing interest in amphiphilic lipid delivery systems based on glyceryl monooleate (GMO) due to its biocompatibility, biodegradability, and bioadhesion [9]. Drug release is achieved in a sustained manner via GMO-based delivery systems. When there is an excess of water present, GMO expands and creates self-assembling liquid crystalline phases due to its high viscosity. The benefits of novel topical administration include increased effectiveness and guaranteed localization or skin penetration of the medication [10].
Tolnaftate, a hydrophobic drug with poor topical bioavailability, is a used to treat certain fungal infections, such as skin infections, including athlete's foot, jock itch, and ringworm. The frequent administration of Tolnaftate hinders patient adherence to treatment. Tolnaftate is classified as a class IV drug having low solubility and low permeability. It is insoluble in water. It is a chemically anti-fungal drug. This study aimed to formulate and evaluate cubosomes as skin retentive system for topical delivery of Tolnaftate [11, 12].
MATERIALS AND METHODS
Materials
Tolnaftate was a gift sample from Aarti Drugs Limited, Mumbai, India, Glycerol monooleate (GMO) was a gift sample from Mohini Organics Pvt. Ltd, India. Poloxamer 407 (Pluronic F 127), Carbopol 934 and Triethanolamine were procured from Sigma-Aldrich Corp., India. All other chemicals, reagents and solvents used were of analytical grade.
Table 1: Formulation batches
| S. No. | Poloxamer 407 (mg) | Glycerol monooleate (mg) |
| 1 | 100 | 3.0 |
| 2 | 150 | 3.0 |
| 3 | 200 | 3.0 |
| 4 | 100 | 3.5 |
| 5 | 150 | 3.5 |
| 6 | 200 | 3.5 |
| 7 | 100 | 4.0 |
| 8 | 150 | 4.0 |
| 9 | 200 | 4.0 |
Method
Formulation of tolnaftate-loaded cubosomes
Tolnaftate-loaded cubosomes were formulated by emulsification techniques, shown in fig. 1. Different quantities of Poloxamer 407 was utilised as a nonionic surfactant and lipid monoglyceride (glycerol monooleate) as a stabiliser. GMO was melted in one beaker at temperatures (around 50 °C) in a magnetic stirrer at 500 rpm. In which drug was added to this solution until complete solubilization. Poloxamer 407 was melted in second beaker at 50 °C. GMO and drug-containing solution were added to this mixture, and it was agitated using a magnetic stirrer at 500 rpm until a clear surfactant solution formed in the greasy mass. In this lipid mass, preheated distilled water was added by dropwise (with the help of syringe or dropper) to form milky dispersion and the volume was adjusted up to 20 ml. With constant stirring, a stable cubosomal dispersion emulsion developed. After the formation of cubosomal dispersion, the solution is homogenized for 10 min. After homogenization, solution is sonicating (By using probe sonicate) for 5 min for reduction of vesicle size [13, 14].

Fig. 1: Graphical representation of tolnaftate-loaded cubosomes prepared by emulsification techniques
Scale-up studies
A trial-based approach was undertaken in order to preserve the drug-lipid ratio. Initially, the batch size was raised while maintaining the same ratio of surfactant to lipid concentration and all other process parameters. Scaling up to 100 ml was done using the improved batch composition as a basis. The resultant cubosomal dispersion was then submitted to further characterization investigations, as shown in fig. 2.
Characterization of tolnaftate loaded cubosomes
Physical appearance
Cubosomal gel was visually evaluated for colour and texture.
Determination of pH
The pH of the gel was measured using a pH meter. The pH meter was calibrated with buffered solutions at pH 4, 7, and 10 before each use.

Fig. 2: Scale up batch (100 ml volume)
Viscosity
The viscosity of gel was determined on spindle 64 using a Fungilab viscometer (Fungilab expert series serial EXPL 3000050, code V300003, Spain). Rotation speed of 10, 20, 50, and 100 rpm. Before taking measurements, the gel measurement samples were allowed to settle for 30 min at room temperature.
Drug content
The drug content of Cubosomal COL gel was evaluated by dissolving 1 g of gel in 9 ml ethanol and centrifuging the sample for 1 hour at 4000 rpm. After centrifugation, the filtrate was filtered and spectrophotometrically analyzed at max 257 nm.
Particle size, polydispersibility index and zeta potential
Light scattering in motion (Nano zetasizer SZ-100 (Horiba nanosizer analyzer, Japan) is used to determine the PS, ZP and PDI of Cubosomal formulation. Prior to analysis, materials were diluted with filtered water to a scattering intensity of 150-300 kcps at 25 °C. The PS (z-average) and PDI were calculated in triplicate.
Entrapment efficiency
The RM 12-LC cooling centrifuge from Remi Motors was used to centrifuge samples from each batch for 30 min at 10,000 rpm. PBS (pH 6.8) was used to dilute aliquots from each batch's supernatant. After analysing Using a UV spectrophotometer (UV 750, Shimadzu Japan) set to maximum 257 nm, the drug concentration in the diluted supernatant was determined. The entrapped drug quantity was estimated using the following equation,
EE (%) = C (total drug concentration) – C (free drug)/C (total drug concentration) x 100
Fourier transform infrared spectroscopy (FTIR)
The distinctive functional group was identified using this technique using spectral bands. As the peak intensity gives a clear indication of the kind of material present, it is an excellent tool for qualitative investigation. Using dried potassium bromide, the baseline correction was performed. Then the spectrum of mixture of drug and potassium bromide was run followed by drug with excipients (physical mixture) and percentage transmittance studied in the spectral region of 4000-400 cm-1utilizing scans at 40 cm-1 and 4 cm-1 resolutions.
Differential scanning calorimetry (DSC)
DSC is a popular analytical technique for determining energy transferred to or from a sample undergoing physical or chemical transformation. It is also used to identify physical characteristics, thermal transitions, glass transition temperatures, and latent heat of materials. The difference in heat flow to the temperature was used to measure both the sample and the reference. In general, DSC is a potent analytical method for determining the purity, stability, and compatibility of a medication with its excipients. Thermogram of the drug, tolnaftate, excipients, and final formulation were acquired using SDT Q600 V20.9 Build 20, India.
X-ray diffraction (XRD)
This is utilized for primary characterization of material features such as crystal texture, crystal defect, crystalline, and molecular strains. X-ray beam that was emitted from the lattice planes at an angle. The atoms along the X-ray route under investigation scattered or diffracted the X-ray beam that passed through the substance. Using Bragg's law and a correctly positioned detector, the interference generated by X-ray scattering is seen, and the material's crystalline structural characteristics are estimated. Performed an XRD investigation of tolnaftate with additional excipients and with the final formulation by using Brucker.
Transmission electron microscopy (TEM)
Transmission electron microscopy (TEM) was used to investigate the LCZ-NE's distinctive morphology (Joel JEM 1230, Tokyo, Japan). Following sufficient dilution, a drop of cubosomes loaded with tolnaftate was placed on a copper grid coated with carbon and allowed to sit for two minutes. The extra liquid was removed using filter paper. After the carbon grid was allowed to air dry at room temperature, the sample was negatively stained with a drop of 2% phosphotungstic acid solution and placed into the TEM apparatus for observation.
Preparation of cubosomal gel
The required amount of Carbopol 934 was weighted; Carbopol 934 was then gently put in a beaker containing distilled water (20-40 ml) while stirring. The mixture was continually stirred until a gel formed. Cubosomal formulation was progressively added to the prior carbopol solution while stirring at 500 rpm. The pH was then adjusted with 0.5% triethanolamine. Propylene glycol, a penetration enhancer, has been added, glycerol and methylparaben have been added as a preservative.
Formulation of tolnaftate plain gel
The required amount of Carbopol 934 was weighted; carbopol 934 was then gently put in a beaker containing distilled water (20-40 ml) while stirring. The mixture was continually stirred until a gel formed. Precisely weighted Tolnaftate The drug solution was dissolved in ethanol, and the ethanolic drug solution was gradually added to the preceding carbopol solution while stirring at 500 rpm. The pH was then adjusted with 0.5% triethanolamine. Propylene glycol, a penetration enhancer, has been added, glycerol and methylparaben have been added as a preservative, formulation shown in fig. 3.


Fig. 3: Formulation of cubosomalhydrogel of optimized batch F9
In vitro drug release study
The investigations of formed cubosomes were assessed using a Franz diffusion cell. A cellulose acetate membrane with a molecular cut-off of 10,000 Da was utilized. Phosphate buffer saline of pH 6.8 was used as the diffusion medium. TOL cubosomes (equal to 100 mg) were added into the donor compartment while the receptor compartment with phosphate buffer 6.8 was agitated at 100 rpm. 1 ml aliquots from the receptor compartment were withdrawn at regular intervals. To maintain the sink state, an equivalent amount of phosphate buffer was added. Using a UV-spectrophotometer set at 257 nm, aliquots were tested for TOL. Each experiment was carried out three times in a row.
Ex vivo permeation study
The experiments of developed cubosomal gel, tolnaftateplain gel, and commercialized formulation were conducted on animal skin (goat ear skin) for a 24 h period using 10 ml of PBS pH 6.8 as diffusion medium. Hairless animal skin (goat ear skin) was clean and cut in 1.73 cm3 diameter and place into diffusion apparatus. A Cubosomal gel of TOL was spread into the donor compartment while the receptor compartment contains phosphate buffer 6.8 was agitated at 100 rpm. At regular intervals, 1 ml aliquots were extracted and replenished from the receptor compartment. To retain the sink state, add an equal amount of fresh medium. Withdrawn aliquots were then tested for TOL using a UV-Spectrophotometry method at 257 nm. Every experiment was run three times consecutively.
Anti-fungal study
Antifungal activity against Candida albicans (Well diffusion technique for identifying the zone of inhibition) was carried out [15, 16]. Sabouraud dextrose agar of Hi media was used for the growth of fungus. Media with acidic pH (pH 5.5 to 5.6) containing a relatively high concentration of glucose (40%) is prepared by mixing (SDA) Sabouraud dextrose and distilled water and autoclaved at 121 °C for 15 min.
25 ml of molten (45 °C) SDA medium was aseptically transferred to each 100 mm×15 mm sterile Petri dish. For counting of spore (fungi) were suspended in normal saline to make volume up to1 ml and then counted with help of heamocytometer (neubar chamber). Once the agar was hardened, 6 mm wells were bored using a sterile cork borer. Then 0.1 ml (100 μl) from each stock solution of the sample having a final concentration of 5 mg and 10 mg was placed in each the well and the plates were incubated for 72 h at 29 °C.
RESULTS
Optimization of process parameters
Optimization of concentration glycerol monooleate
GMO content affects the physical appearance and stability of Cubosomal nanoparticles was investigated by using different GMO concentrations such as 3%, 3.5%, and 4%. Due to the desirable physical appearance and stability, 3%, 3.5%, and 4% v/v GMO were found to be appropriate for cubosomal nanoparticles. Table 2 displays the ratios.
Table 2: Concentration of glycerol monooleate
| S. No. | GMO | Pol 407 | Physical appearance | Stability |
| 1 | 3 | 1 | Milky white low viscous dispersion | No change |
| 2 | 3 | 1.5 | Milkywhite low viscous dispersion | No change |
| 3 | 3 | 2 | Milkywhite low viscous dispersion | No change |
| 4 | 3.5 | 1 | Milkywhite low viscous dispersion | No change |
| 5 | 3.5 | 1.5 | Milky white viscous dispersion | No change |
| 6 | 3.5 | 2 | Milky white viscous dispersion | No change |
| 7 | 4 | 1 | Highlyviscous dispersion | No change |
| 8 | 4 | 1.5 | Highlyviscous dispersion | No change |
| 9 | 4 | 2 | Highlyviscous dispersion | No change |
Optimization of poloxamer 407 concentration
The amount of stabilizer employed influences the characteristics containing Cubosomal nanoparticles [17]. If the concentration is insufficient, the cubosomes will have different phases, whereas when the concentration is increased, the medication and the stabilizer interact, resulting in less integration of medication.
Various doses of stabilizer (0.1 %, 0.15 %, and 0.2 %) were optimized, and the findings revealed that 0.1 %, 0.15 %, and 0.2 % were adequate to achieve a stable cubosomes formulation. Table 3 displays the ratios.
Table 3: Concentration of poloxamer 407
| S. No. | Pol 407 | GMO | Physical appearance | Stability |
| 1 | 1 | 3 | Milky white low viscous dispersion | No change |
| 2 | 1 | 3.5 | Milky white low viscous dispersion | No change |
| 3 | 1 | 4 | Milky white low viscous dispersion | No change |
| 4 | 1.5 | 3 | Milky white low viscous dispersion | No change |
| 5 | 1.5 | 3.5 | Milky white viscous dispersion | No change |
| 6 | 1.5 | 4 | Milky white viscous dispersion | No change |
| 7 | 2 | 3 | Highly viscous dispersion | No change |
| 8 | 2 | 3.5 | Highly viscous dispersion | No change |
| 9 | 2 | 4 | Highly viscous dispersion | No change |
Characterization of cubosomal dispersion
Drug content
The drug content was 99.69 %. To verify formulation consistency, the drug concentration of tolnaftatecubosomal gel of the optimum batch was evaluated using UV spectroscopy. The drug content indicated that the medicine was spread uniformly throughout the formulation. The allowable drug content ranges from 85% to 115% of the average.
Viscosity measurement
At 10, 20, 50, and 100, the cubosomal gel viscosity was 18236, 5999, 2383, and 1500 (cP), which is within the optimal gel viscosity range.
Particle size, polydispersibility index and zeta potential
A computerized zeta sizer and the dynamic light scattering technique were used to measure the particle size and polydispersity index of cubosomes. All formulations have particle sizes in the range of nanometers. The optimized batch's typical particle size was determined to be 208.6 nm, with a PDI of 0.440.
A zetasizer was used to find the electrophoretic mobility (zeta potential) of cubosomal dispersions. The zeta potentials were within the normal range. Because of use of GMO and the poloxamer 407 as a stabilizer in solution, the results show that the particles have a balancing charge. The formulation's zeta potential is utilized to forecast the nanoparticles' stability. The results show that the composition does not generate aggregation. Poloxamer 407, a surface stearic stabilizer produces a coating on the nanoparticles' surfaces, preventing them from aggregating. As a result, the formulation (F9) was detected to have+49.8 mV and was determined to be more stable than other formulations.
Entrapment efficiency
The formulation's effectiveness of trapping was assessed by the properties of the lipid, drug, and stabilizer. Cubosomes were subjected for centrifugation for 1 h at 10,000 rpm. Supernatant rich in unentrapped drug was isolated and quantified at 257 nm using a UV spectrophotometer. All batches' entrapment efficiency varied from 59.6 to 90.5%. The F9 formulation demonstrated entrapment efficiency at its peak. Due to the lipophilic nature of the drug, the entrapment efficiency of the formulations improved when bigger doses of GMO were utilized. Similar results were reported by some authors [18-20]. The higher lipid levels would improve lipophilic drug solubilization and give more area for drug entrapment.
Table 4: Vesicle size, PDI, zeta potential and entrapment efficiency of all 9 batches
| Formulation no | Particle size (nm) | PDI | Zeta potential (mV) | Entrapment efficiency (%) |
| F1 | 263.6±0.01 | 0.437±0.0004 | +43.3±0.01 | 59.6±0.02 |
| F2 | 269.7±0.01 | 0.407±0.0001 | +44.1±0.01 | 73.8±0.02 |
| F3 | 274.2±0.02 | 0.402±0.0001 | +45.3±0.02 | 76.9±0.01 |
| F4 | 234.0±0.01 | 0.428±0.0002 | +46.2±0.01 | 74.4±0.02 |
| F5 | 221.4±0.02 | 0.456±0.0002 | +45.2±0.01 | 77.3±0.01 |
| F6 | 220.1±0.02 | 0.439±0.0010 | +46.2±0.05 | 87.9±0.01 |
| F7 | 240.1±0.01 | 0.562±0.0008 | +47.4±0.01 | 87.1±0.01 |
| F8 | 221.7±0.02 | 0.422±0.0010 | +48.2±0.02 | 89.6±0.01 |
| F9 | 208.6±0.01 | 0.440±0.0015 | +49.8±0.01 | 90.5±0.6 |
Fourier transform infrared spectroscopy (FTIR)
The FTIR study was performed to validate the potential of chemical bond interaction between the drug and the excipients contained in the formulation. Formulations shown in fig. 4, the FTIR study concluded that drug; surfactant/lipid and cubosomes displayed the expected bands, confirming absence of interaction between tolnaftate, lipid (GMO) and surfactant/Polymer (Poloxamer 407).

Fig. 4: FTIR spectrum of cubosomal formulation (F9), TOL and excipients. (Overlay graph)
Differential scanning calorimetry (DSC)
The DSC thermal profile of pure TOL showed a strong endothermic peak at 114.88 °C, which was caused by the melting transition point of TOL during the DSC test, fig. 5. The DSC thermal profile of drug-loaded cubosomes revealed that TOL peaked at 102.44 °C, GMO peaked at 286.66 °C, and Poloxamer 407 peaked at 56.36 °C. The presence of a change or modest shift in drug peaks with lower intensity suggested that TOL entrapment in cubosomes was caused by a modest reduction in crystallinity, which might be attributable to molecular dispersion or a soluble form of drug in the hydrophilic center of the cubosomes. The enthalpy change value for pure TOL was greater than cubosomal, suggesting that the drug was molecularly disseminated in cubosomes and transformed to an amorphous state.

Fig. 5: DSC thermogram of cubosomal formulation (F9), Drug, GMO and poloxamer 407
X-ray diffraction (XRD)
X-ray diffraction patterns of the produced cubosomal dispersion, as well as pure TOL, GMO, and P407 samples, were obtained using an X-ray diffractometer. To confirm the physical state of TOL, X-ray diffraction patterns of produced TOL-loaded cubosomes as well as pure drug powder samples were obtained (fig. 6). The diffract g of pure TOL clearly showed strong characteristic peaks in the range of 10-30°; however, those characteristic peaks vanished in TOL loaded cubosomes, indicates that the drug is either molecularly dispersed in cubosomes or has become amorphous.

Fig. 6: XRD diffractograms of cubosomal formulation (F9), Drug, GMO and poloxamer 407



Fig. 7: TEM images of tolnaftate loaded cubosomes F9
Transmission electron microscopy (TEM)
Morphology analysis of TOL-loaded cubosome formulation revealed nanoparticles with spherical morphology and polyangular forms fig. 7.
In vitro drug release
All cubosomal formulations (CUB F1-F9) were tested in vitro in phosphate buffer (pH 6.8) utilizing a dialysis membrane. The dialysis membrane was used to conduct release experiments on cubosomal formulations. The structure and characteristics of lipids were revealed to affect drug release. At the conclusion of 24 h, a maximum of 79.4% of the drug was released, showing sustained delivery. This prolonged-release might be attributed to the lipophilic drug's high trapping in the lipid matrix [21]. Because F9 had the highest drug release, it was chosen as the best formulation and would be utilized in future trials fig. 8 depicts the picture.

Fig. 8: Graph of in vitro drug release study of cubosomes formulation (F1-F9)
Similarly, in vitro drug release from plain gels loaded with tolnaftate and commercialized formulation was determined to be 92.0% and 77.53%
Cubosomal gel in vitro drug release kinetics matches the Korsmeyer Peppas mode kinetic with the highest R2 value 0.807; this prolonged release might be owing to the strong trapping of the lipophilic drug in the lipidic matrix. Fig. 9 depicts the picture.
Ex vivo permeation study
For the ex vivo permeation research, an optimized batch (F9) of cubosomal dispersion was employed. 92.00% of the total medication penetrated through the skin in the cubosomal gel formulation. Because of the occlusive nature of cubosomalnanocarriers, improved penetration is envisaged. The drug steady-state flux (Jss) values for Tolcubosomal formulation, marketed formulation, and plain drug gel were nearly 11.98, 10.23, and 10.06 g/cm2. h, In the meanwhile, the permeability coefficients (kp) for TolCubosomal formulation, commercialized formulation, and plain drug gel were 2.34, 2.04, and 2.01 cm/h, respectively, as reported in table 5. The high Jss and kp values for Cubosomal formulation may be attributed to the high quantities of GMO and P407 in formulation as compared to other formulations, plain medication gel and commercialized formulation. As compared to standard marketed preparation, the cubosome-loaded formulation demonstrated enhanced penetration, extended deposition, and prolonged drug release (fig. 10), which might be attributed to the intrinsic features of the proposed Cubosomal formulation.

Fig. 9: Graph of % CDR of cubosomal gel, plain drug gel and marketed formulation

Fig. 10: Graph of ex vivo permeation study of cubosomal gel, plain drug gel and marketed formulation
Table 5: Steady state flux and permeation coefficient (Cubosomal gel, plain drug gel, marketed formulation) (mean±SD, n=3)
| Formula | JSS(µg/cm2. h) | Permeability coefficient (cm/h) |
| Cubosomal gel | 11.98±0.02 | 2.39±0.01 |
| Plain drug gel | 10.06±0.01 | 2.01±0.01 |
| Marketed formulation | 10.23±0.03 | 2.04±0.02 |
Table 6: Antifungal activity of samples against candida albicans.
| S. No. | Samples | Concentration | zone in diameter (mm) against candida albicans |
| 1 | Control | - | - |
| 2 | Tolnaftate plain gel | 1 mg | 1 |
| 5 mg | 08 | ||
| 10 mg | 14 | ||
| 3 | Tolnaftatecubosomal gel | 1 mg | 1 |
| 5 mg | 04 | ||
| 10 mg | 10 |
Anti-fungal study
The antifungal activity was assessed as the diameter (mm) of the clear zone of growth inhibition displayed in table 6.
Images of the zone of inhibition are shown in fig. 11. For Tolnaftate plain gel and Tolnaftatecubosomal gel formulation, the zone of inhibition was determined to be 1 mm, 08 mm, 14 mm at 1 mg, 5 mg, and 10 mg, and 1 mm, 04 mm, and 10 mm at 1 mg, 5 mg, and 10 mg, respectively. These results indicate that Tolnaftatecubosomal gel has a lower zone of inhibition than Tolnaftate plain gel. This could be as a result of the drug being more available in plain gels than it was in cubosomal gels, where the drug is located in vesicles. Because of this, the plain gel formulation has a bigger zone of inhibition than the cubosomal gel formulation.
Fig. 11: a) Antifugal study of tolnaftate plain gel, b) Antifugal study of Tolnaftatecubosomal gel
Stability study
Stability studies shall be passed out in compliance with the ICH guidelines. Here for formulated samples of optimized batch F9. A three-month stability study was carried out at controlled room temperature (25 °C-2 °C, 60%-5% RH). Cubosomal gel formulation was tested for pH, viscosity, drug content, particle size, and Zeta potential during a three-month period. The obtained results were showed in below table 7 and result shows Formulation was stable after 3 mo.
Table 7: Stability study of cubosomal gel of F9 formulation.
| S. No. | Evaluation parameter | Time interval | |
| 0 d (Initial) | 90 d (after 3 Mo) | ||
| 1 | pH | 5.83±0.01 | 5.89±0.02 |
| 2 | Viscosity (spindle 64 at 100 rpm) | 1500±1.0 | 1563±0.12 |
| 3 | Drug content (%) | 99.69±0.02 | 98.5±0.03 |
| 4 | Particle size (nm) | 208.6±0.01 | 221.8±0.02 |
| 5 | Zeta Potential (mV) | +49.8±0.01 | +49.5±0.01 |
DISCUSSION
The aim of this study was to investigate the potential use of nanocrystalline cubosomes to improve the bioavailability of tolnaftate and to provide the patient with a once-daily dose. The goal is predicted to be met due to the unique features of cubosomes, which allow tolnaftate to pass through the skin's anatomical and physiological barriers.
Tolnaftate is an antifungal agent used to treat skin infections such as athlete's foot, jock itch, and ringworm. It is BCS class IV drug having less solubility and less permeability. The stratum corneum, where pathogens live, is the location of tolnaftate activity. However, the stratum corneum's specific character makes it an effective barrier for drug penetration. As a result, the rate-limiting step in topical medication absorption is stratum corneum penetration. Tolnaftate for the treatment of fungal infections, is often prepared as a 1% cream, lotion, spray, or solution. While the options are still limited compared to other antifungal medications that might offer more versatile forms such as nanocarriers, gels, or nail lacquers. Tolnaftate is a poorly soluble drug, e. g., the solubility in wateris<1 mg/100 ml. Hence, it requires a suitable vehicle to increase its topical absorption.
Conventional tolnaftate formulations, such as creams, powders, and sprays, have several disadvantages. Such as poor penetration, frequent application, residue and greasiness, variable absorption, limited targeting and stability issues that may limit their effectiveness and user satisfaction.
Only few researchers have developed liposomes and emulgel [22, 23] of tolnaftate. However, these formulations have poor encapsulation and stability as they are prone to leakage. Considering these drawbacks, advancements in drug delivery systems, such as cubosomal gels, aim to address many of these limitations by enhancing penetration, providing sustained release, and improving overall efficacy and user experience. This could lead to more effective and longer-lasting treatment of fungal infections with potentially reduced side effects compared to traditional formulations.
Because of the structural similarities between the bicontinuous structures formed in human skin layers and those comprising cubic phases, cubosomes, due to their unique shape and features, offer a potential vehicle for topical medication administration. Formulating hydrophobic drugs into cubosomes is a safe and promising approach by incorporating it into lipidbilayer of cubosomes, which enhances the solubility, permeability and stability. Furthermore, cubosomes enable continuous drug release and extend drug skin residence duration. Because of these qualities, typical topical treatments 'problems (dose loss and high dosage frequency) are avoided.
Formulation of cubosomes containing tolnaftate, poloxamer 407, and glycerol monostearate involves creating a structured system where these components work together to enhance the delivery and effectiveness of the antifungal agent. By combining the advanced delivery capabilities of cubosomes with the gelling and bioadhesive properties of Carbopol 934, a highly effective and patient-friendly topical formulation can be created.
GMOs were used to create these cubosomes. Concentrations ranging from 3% to 4% and Poloxamer concentrations ranging from 0.1% to 0.2%. Nine formulations were created by adjusting its concentration to achieve the best formulation in terms of physical appearance, stability, particle size, and entrapment efficiency. The average particle size was reduced from 263.6 to 208.6 nm by employing Poloxamer 407 at concentrations ranging from 0.1 to 0.2 Because Poloxamer 407 is a hydrophilic nonionic surfactant and a block copolymer of polyethylene oxide (PEO) and polypropylene oxide (PPO), the PPO chains adsorb on the particle surface while the PEO chains pull away from the surface of the aqueous medium [24]. The particle size is affected by surfactant content. It was discovered that 0.2 % Poloxamer407 was the optimal concentration for cubosomes production, with an entrapment effectiveness of around 90.5% and an average particle size of approximately 208.6 nm.
The optimized cubosomes formulation had the necessary physicochemical qualities, such as particle size analysis, which was obtained in a satisfactory nano range. The cubosomes created had a smooth surface and a cubic shape, which was observed. TEM images of the optimized formulation indicate a spherical and cubic structure. Azetasizer was used to evaluate thee lectrophoretic mobility (zetapotential) of Cubosomal dispersions. The zeta potentials were within the expected range. Because of the employment of Poloxamer 407 as a stabilizer and GMO in solution, the particles have a neutral charge, according to the data.
The zeta potential of the formulation is used to predict the stability of the nanoparticles. Because of the use of a surface stearic stabilizer, Poloxamer 407, the results suggest that the formulation does not cause aggregation. It produces a coating on the nanoparticles' surfaces, preventing them from aggregating. As a result, the formulation (F9) was detected with-+49.8 0.01mv and was discovered to be more stable than other formulations.
The in vitro release testing lasted 24 h, and the cumulative drug release from the improved cubosomes formulation exhibited a release percentage of around 79.4%. It demonstrates the cubosomes formulation's prolonged release effect,as it only releases roughly 79.4% in 24 h.
The release data after fitting into several kinetic models such as zero order, first order, Higuchi's model, and Korsemeyer-Peppas model. Korsmeyer and Peppas' kinetic graphs were found to be fairly linear, as indicated by their highest regression value (0.879) for ideal formulation. In this study, the in vitro drug release of an enhanced cubosomal formulation matched the kinetic model of Korsemeyer and Peppas. The "n value" shows non-ficki and iffusion. Cubosomalgel was the nmadeutilizingth is justed composition. Formulation F 9 was put into a Carbopol 934 and Glycerol gel. The physical appearance of these Cubosomalgels 'pH, viscosity, drug content, in vitro drug release study, ex vivo permeation study and, kinetic studies, and antifungal study were all examined. The Cubosomal gel's average pH was measured to be 5.83±0.01. The viscosity was calculated to be 182361.0, 59990.6, 23830.6, and 15001.0, At 10, 20, 50, and 100 rpm, respectively. The drug concentration in the formed gel was determined to be 99.69%usingthe optimized method.
At the end of a 24 h in vitro release assay, the formulated Cubosomal gel had a release rate of 92.0%. When these data were put into kinetic release models after the release, it was discovered that they followed the Korsemeyer-Peppasmodel. The kinetic plots of Korsmeyer and Peppas were found to be very linear, as demonstrated by the highest regression value (0.807) for the optimized formulation. Its "n value" shows non-fickian diffusion.
Ina24 h examination, ex-vivo penetration was determined to be 92.00% over the skin. Cubosomalgel has improved permeability properties. The antifungal activity of the material was determined using an agar well diffusion test. For To lnaftate plain gel and Tolnaftatecubosomal gel formulation, the zone of inhibition was determined to be 1 mm, 8 mm, 14 mm at 1 mg, 5 mg, and 10 mg, and 1 mm, 4 mm, and 10 mm at 1 mg, 5 mg, and 10 mg, respectively. The stability study was conducted for three months of consistency. The experiment was carried out at a controlled room temperature (25 °C, 2 °C, 60%, 5% RH). Cubosomal gel formulation was tested for pH, viscosity, drug content, particle size, and Zeta potential during a three-month period. And the result shows Formulation was stable after 3 mo.
CONCLUSION
In the present study, drug's poor permeability and solubility were overcome and better results were obtained in the form of cubosomes, which significantly improved the drug's permeability and solubility. The improved formulation's cubosomal gel outperformed cubosomal dispersion. As a result, it is concluded that the efficiency of tolnaftate for the treatment of ringworm fungal infection is improved when administered in the form of cubosomal gel. In the future, in vivo studies can be carried out to acquire a better understanding of the formulations and their characteristics.
FUNDING
Nil
AUTHORS CONTRIBUTIONS
CONFLICT OF INTERESTS
Declared none
REFERENCES
Jain S, Jain V, Mahajan SC. Lipid-based vesicular drug delivery systems. Adv Pharm. 2014;2014:1-12. doi: 10.1155/2014/574673.
Ashara KC, Paun JS, Soniwala MM, Chavda JR, Nathawani SV, Mori NM. Vesicular drug delivery system: a novel approach. Mintage J Pharm Med Sci. 2014:3(3):1-14.
Harshini B, Harshini B, Kumari PV, Rao YS. Review on cubosomes. Int J Curr Pharm Res. 2021;13(6):37-42. doi: 10.22159/ijcpr.2021v13i6.1926.
Spicer PT, Hayden KL, Lynch ML, Ofori Boateng A, Burns JL. Novel process for producing cubic liquid crystalline nanoparticles (cubosomes). Langmuir. 2001;17(19):5748-56. doi: 10.1021/la010161w.
Kamboj S, Saini V, Magon N, Bala S, Jhawat V. Vesicular drug delivery systems: a novel approach for drug targeting. Int J Drug Deliv. 2013;5(2):121-30.
Garg G, Saraf S, Saraf S. Cubosomes: an overview. Biol Pharm Bull. 2007;30(2):350-3. doi: 10.1248/bpb.30.350, PMID 17268078.
Zakaria F, Ashari SE, Mat Azmi ID, Abdul Rahman MB. Recent advances in encapsulation of drug delivery (active substance) in cubosomes for skin diseases. J Drug Deliv Sci Technol. 2022;68:103097. doi: 10.1016/j.jddst.2022.103097.
Anbarasan B, Grace XF, Shanmuganathan S. An overview of cubosomes smart drug delivery system. Sri Ramachandra J Med. 2015;8(1):1-4.
Gagliardi A, Cosco D, Udongo BP, Dini L, Viglietto G, Paolino D. Design and characterization of glyceryl monooleate nanostructures containing doxorubicin hydrochloride. Pharmaceutics. 2020;12(11):1017. doi: 10.3390/pharmaceutics12111017, PMID 33114287.
Barriga HM, Holme MN, Stevens MM. Cubosomes: the next generation of smart lipid nanoparticles? Angew Chem Int Ed Engl. 2019;58(10):2958-78. doi: 10.1002/anie.201804067, PMID 29926520.
Bhosale RR, Osmani RA, Harkare BR, Ghodake PP. Cubosomes: the inimitable nanoparticulate drug carriers. Scholars Acad J Pharm. 2013;2(6):481-6.
Gaballa SA, El Garhy OH, Abdelkader H. Cubosomes: composition preparation and drug delivery applications. J Adv Biomed Pharm Sci. 2019;3(1):1-9. doi: 10.21608/jabps.2019.16887.1057.
Spicer P. Cubosome processing industrial nanoparticle technology development. Chem Eng Res Des. 2005;83(11):1283-6. doi: 10.1205/cherd.05087.
HE H, Rahimi K, Zhong M, Mourran A, Luebke DR, Nulwala HB. Cubosomes from hierarchical self-assembly of poly (ionic liquid) block copolymers. Nat Commun. 2017;8(1):14057. doi: 10.1038/ncomms14057, PMID 28091605.
Leung AK, Lam JM, Leong KF, Hon KL. Tinea corporis: an updated review. Drugs Context. 2020;9:5-6. doi: 10.7573/dic.2020-5-6, PMID 32742295.
N Politis S, Colombo P, Colombo G, M Rekkas D. Design of experiments (DoE) in pharmaceutical development. Drug Dev Ind Pharm. 2017;43(6):889-901. doi: 10.1080/03639045.2017.1291672, PMID 28166428.
Nasr M, Younes H, Abdel Rashid RS. Formulation and evaluation of cubosomes containing colchicine for transdermal delivery. Drug Deliv Transl Res. 2020;10(5):1302-13. doi: 10.1007/s13346-020-00785-6, PMID 32399604.
Azhari H, Strauss M, Hook S, Boyd BJ, Rizwan SB. Stabilising cubosomes with tween 80 as a step towards targeting lipid nanocarriers to the blood-brain barrier. Eur J Pharm Biopharm. 2016 Jul;104:148-55. doi: 10.1016/j.ejpb.2016.05.001, PMID 27163239.
Alamoudi JA, Almoshari Y, Alotaibi HF. Formulation and evaluation of pluronic F-127 assisted carboplatin cubosomes. Indian J Pharm Educ Res. 2023;57(4):1258-64. doi: 10.5530/ijper.57.4.150.
Flak DK, Adamski V, Nowaczyk G, Szutkowski K, Synowitz M, Jurga S. AT101 loaded cubosomes as an alternative for improved glioblastoma therapy. Int J Nanomedicine. 2020;15:7415-31. doi: 10.2147/IJN.S265061, PMID 33116479.
Nasr M, Dawoud M. Sorbitol-based powder precursor of cubosomes as an oral delivery system for improved bioavailability of poorly water-soluble drugs. J Drug Deliv Sci Technol. 2016 Oct;35:106-13. doi: 10.1016/j.jddst.2016.06.011.
Kesharwani R, Jaiswal P, Patel DK, Yadav PK. Lipid-based drug delivery system (lbdds): an emerging paradigm to enhance oral bioavailability of poorly soluble drugs. Biomed Mater Devices. 2023;1(2):648-63. doi: 10.1007/s44174-022-00041-0.
Meghana G, Karri VV Satyanarayana Reddy, Talluri Siddhartha, Gunda Raviteja, Chennareddy Saikrishnaand, Ganesh GNK. Formulation and evaluation of tolnaftate-loaded topical liposomal gel for effective skin drug delivery to treat fungal diseases. J Chem Pharm Res. 2014;6(10):856-66.
Verma S, Mujahid M, Farooqui NA, Ahmad S. Formulation and evaluation of topical microemulgel containing tolnaftate. Int J Pharm Sci Rev Res. 2023;83(2):31-40. doi: 10.47583/ijpsrr.2023.v83i02.005.
Chountoulesi M, Perinelli DR, Aleksander Forys, G Bonacucina, Barbara Trzebicka, Stergios Pispas, Costas Demetzos. Liquid crystalline nanoparticles for drug delivery: the role of gradient and block copolymers on the morphology internal organisation and release profile. Eur J Pharm Biopharm. 2021 Jan;158:21-34. doi: 10.1016/j.ejpb.2020.08.008.